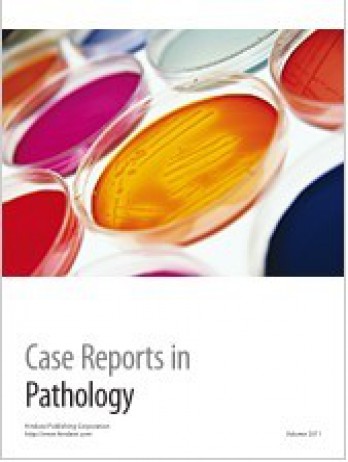

《Case Reports In Pathology》雜志影響因子是:0.7。目前未查詢到中科院分區相關數據,以下是該期刊的其他相關數據:
OA是否開放:開放
Gold OA文章占比:100.00%
是否預警:否
出版語言:English
影響因子:0.7。從影響因子的角度來看,《Case Reports In Pathology》雜志也表現出色,該雜志影響因子在不同年份有所波動,但總體呈上升趨勢,這種趨勢不僅反映了該雜志在學術界的影響力逐漸增強,也體現了其在推動PATHOLOGY領域發展方面的積極作用。
從JCR分區信息的角度,
按JIF指標學科分區分為:PATHOLOGY,分區:Q4,排名:80 / 88,百分位:9.7%;
按JCI指標學科分區分為:PATHOLOGY,分區:Q4,排名:81 / 88,百分位:8.52%;
JCR分區信息
Case Reports In Pathology(2023-2024年最新版數據)
| 按JIF指標學科分區 | 收錄子集 | 分區 | 排名 | 百分位 |
| 學科:PATHOLOGY | ESCI | Q4 | 80 / 88 |
9.7%
|
| 按JCI指標學科分區 | 收錄子集 | 分區 | 排名 | 百分位 |
| 學科:PATHOLOGY | ESCI | Q4 | 81 / 88 |
8.52%
|
湯森路透每年出版一本《期刊引用報告》(Journal Citation Reports,簡稱JCR)。JCR對86000多種SCI期刊的影響因子(Impact Factor)等指數加以統計。JCR將收錄期刊分為176個不同學科類別在JCR的Journal Ranking中,主要參考當年IF,最終每個分區的期刊數量是均分的。